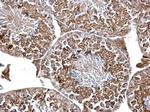
PIK3R4 Antibody in Immunohistochemistry (Paraffin) (IHC (P))

Search
Invitrogen
PIK3R4 Polyclonal Antibody
{{$productOrderCtrl.translations['antibody.pdp.commerceCard.promotion.promotions']}}
{{$productOrderCtrl.translations['antibody.pdp.commerceCard.promotion.viewpromo']}}
{{$productOrderCtrl.translations['antibody.pdp.commerceCard.promotion.promocode']}}: {{promo.promoCode}} {{promo.promoTitle}} {{promo.promoDescription}}. {{$productOrderCtrl.translations['antibody.pdp.commerceCard.promotion.learnmore']}}
产品信息
PA5-21848
宿主/亚型
分类
类型
抗原
偶联物
形式
浓度
保存条件
运输条件
RRID
产品详细信息
PA5-21848 targets p150(PIK3R4) in ICC, IF, IHC (P), and WB applications and shows reactivity with Human and mouse samples.
The PA5-21848 immunogen is a recombinant fragment corresponding to a region within amino acids 1 and 381 of PIK3R4 (Uniprot ID#Q99570).
靶标信息
Regulatory subunit of the PI3K complex that mediates formation of phosphatidylinositol 3-phosphate; different complex forms are believed to play a role in multiple membrane trafficking pathways: PI3KC3-C1 is involved in initiation of autophagosomes and PI3KC3-C2 in maturation of autophagosomes and endocytosis. Involved in regulation of degradative endocytic trafficking and cytokinesis, probably in the context of PI3KC3-C2 (PubMed:20643123). [UniProt]
⚠WARNING: This product can expose you to chemicals including mercury, which is known to the State of California to cause birth defects or other reproductive harm. For more information go to www.P65Warnings.ca.gov.
仅用于科研。不用于诊断过程。未经明确授权不得转售。